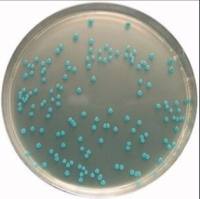
大肠杆菌显色培养基

Novagen公司推出无需IPTG的自动诱导大肠杆菌培养基
互联网
2494
- 相关专题
- 细胞培养基的配制 大肠杆菌的基因工程
最近Novagen公司推出两种过夜培养自动诱导细胞表达的培养基系统,这两种培养基都可以最大程度上提高pET系列和其它IPTG原核诱导表达系统在大肠杆菌 中蛋白的表达量,其最大的方便之处在于使用这种培养基不需要对大肠杆菌 的生长密度进行检测。因为IPTG会对细胞存在毒性,因此使用了这种不含IPTG的自动诱导体系培养基与传统培养基相比可以使细胞数量和目的蛋白量都大大增加数倍。
这种培养基是基于F. William Studier博士的技术,使用了不同代谢成分提高细胞的生长密度,并自动诱导lac启动子开始转录 。Overnight Express Instant TB Medium培养基现在提供三种不同的成分。作为一种粉末装TB培养基它可快速溶解在水中,并进行微波加热和高压灭菌处理。